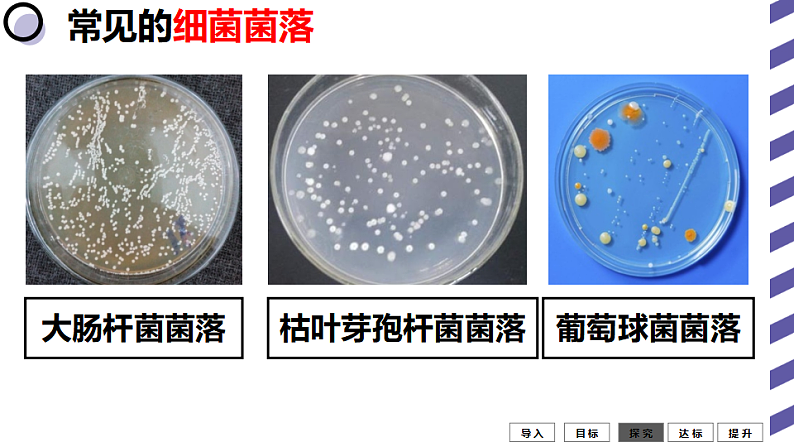
人教版八年级生物上册  5.4.1细菌和真菌的分布（35张PPT）06
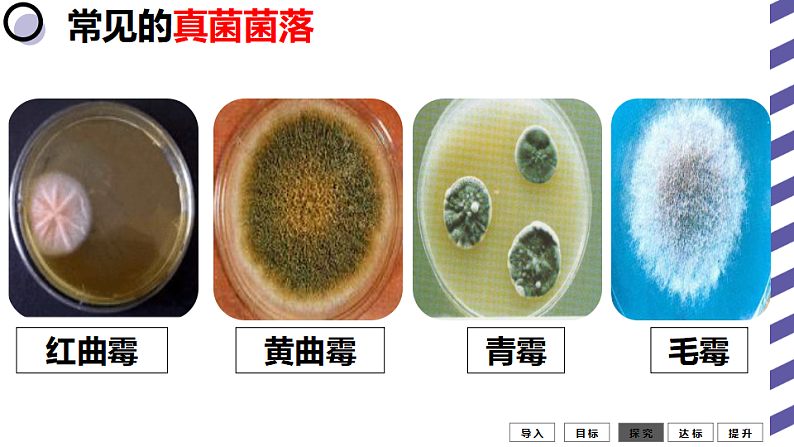
人教版八年级生物上册  5.4.1细菌和真菌的分布（35张PPT）07

生物八年级上册第一节 细菌和真菌的分布教案配套课件ppt
展开初中生物人教版 (新课标)八年级上册第五单元 生物圈中的其他生物第四章 细菌和真菌第一节 细菌和真菌的分布教课ppt课件: 这是一份初中生物人教版 (新课标)八年级上册第五单元 生物圈中的其他生物第四章 细菌和真菌第一节 细菌和真菌的分布教课ppt课件,共23页。PPT课件主要包含了树生木耳,想一想,课题一,观察总结,不同形态的菌落,细菌菌落,霉菌菌落,形态大小颜色,细菌的菌落,真菌的菌落等内容,欢迎下载使用。
初中生物人教版 (新课标)八年级上册第一节 细菌和真菌的分布多媒体教学ppt课件: 这是一份初中生物人教版 (新课标)八年级上册第一节 细菌和真菌的分布多媒体教学ppt课件,共35页。PPT课件主要包含了腐烂的水果,自养细菌,厌氧菌等内容,欢迎下载使用。
人教版 (新课标)八年级上册第五单元 生物圈中的其他生物第四章 细菌和真菌第一节 细菌和真菌的分布教课ppt课件: 这是一份人教版 (新课标)八年级上册第五单元 生物圈中的其他生物第四章 细菌和真菌第一节 细菌和真菌的分布教课ppt课件,共35页。PPT课件主要包含了腐烂的水果,自养细菌,厌氧菌等内容,欢迎下载使用。